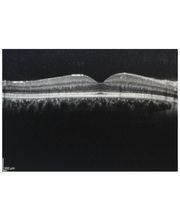
Gallery Cliente

Ramezzana Lorenzo e Zavattaro Gabriella Studio Medico Chirurgico
Fisioterapia · Medico
Via Sangiorgio Benvenuto 32, 15033 Casale MonferratoOculista
+393479038705 (Telefono)
La dott.ssa Scatassi Ilaria è Dirigente Medico presso il Presidio Ospedaliero di Casale Monferrerato (ASL AL). Specializzata in Oculistica la dottoressa si occupa di retinopatie, maculopatia, presbiopia, astigmatismo, miopia e cataratta. Lo Studio della dottoressa Scatassi Ilaria effettua anche visite specialistiche per bambini. Riceve su appuntamento.

Via Benvenuto Sangiorgio, 38, 15033 Casale Monferrato
Fisioterapia · Medico
Via Sangiorgio Benvenuto 32, 15033 Casale MonferratoVendita al dettaglio
Via Benvenuto S.Giorgio. 38, 15033 Casale MonferratoScuola · Autorità · Scuola primaria
Via Pinelli 3, 15033 Casale Monferrato